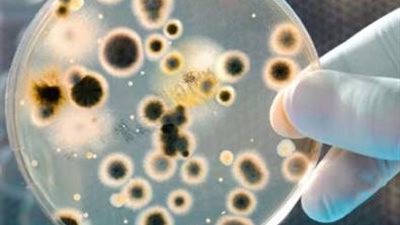
أهم أخبار الاردن اليوم .. نسب الجراثيم بالأردن تفوق مثيلاتها بالمنطقة

عاجل
"القاهرة الإخبارية": سلاح الجو الإسرائيلي يجهز لمهمة غير مسبوقة فوق طهران
انتشال جثمان صغير غرق في ترعة ناصر بالبحيرة
خلافات جيرة تتحول لمشاجرة بسلاح أبيض في حلوان.. الأمن يضبط المتهمين
بدء جلسة النواب لمناقشة تعديلات قانون الضريبة على العقارات المبنية
أوقاف القليوبية تطلق تحدي «أفضل مقرأة قرآنية» وتمنح الفائز تكريمًا من وزير الأوقاف